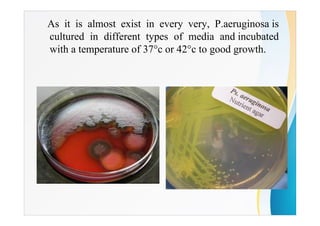
As it is almost exist in every very, P.aeruginosa is
cultured in different types of media and incubated
with a temperature of 37°c or 42°c to good growth.

Pseudomonas aeruginosa is a rod-shaped, Gram-negative bacterium that can infect humans and plants. It is a common opportunistic pathogen that infects wounds, burns, the urinary tract, and lungs. It produces several characteristic pigments and is resistant to many antibiotics. It grows readily in culture at temperatures of 37°C or 42°C. A new biological bandage has been developed that incorporates dendrimer molecules to destroy P. aeruginosa bacteria and prevent infections in burn patients during wound healing.